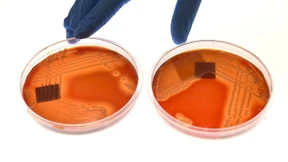
Eine Lebensretter-Maschine auf Station

RKI erwartet Corona-Medikament
Ein Impfstoff wird nach Einschätzung des Robert-Koch-Instituts aber erst nächstes Jahr verfügbar sein. Bis Donnerstagmittag wurden 350 Fälle in Deutschland gemeldet.

Ein Impfstoff wird nach Einschätzung des Robert-Koch-Instituts aber erst nächstes Jahr verfügbar sein. Bis Donnerstagmittag wurden 350 Fälle in Deutschland gemeldet.

Ein neuartiges Virus treibt uns um. Wer ist besonders gefährdet, wie schütze ich mich am besten? Wir haben für Sie die 13 wichtigsten Fragen und Antworten zum Thema.

Robert Schade vom Robert-Koch-Institut teilte am Dienstagmorgen neue Erkenntnisse zur weltweiten Verbreitung des Coronavirus mit.

„Blamable“ Materialversorgung und unzureichende Kinderbetreuung: Bei Frank Plasbergs „hart aber fair“ zur Corona-Epidemie geht es um mehr, als sich für eine angeblich gute Vorbereitung auf die Schulter zu klopfen.

Das Virus breitet sich in Deutschland weiter aus – damit steigt auch die Angst vor einer Ansteckung. Tipps, mit denen Sie sich selbst und andere schützen können.

Die Deutschen decken sich mit Lebensmitteln ein – aus Sorge, dass sie in Quarantäne müssen. Auch die Bahn und die Bundeswehr bereiten sich auf eine mögliche Epidemie vor.

Im hessischen Lahn-Dill-Kreis wurde der Erreger Sars-CoV-2 bei einer Person bestätigt. Der Gesundheitszustand des Mannes ist stabil. Bei einem Ehepaar im Rhein-Taunus-Kreis bestätigte sich der Verdacht nicht.

Das Coronavirus hat weltweit derzeit mehr als 80.000 Menschen befallen. Der Vize-Präsident des Instituts informierte am Freitag in Berlin über die aktuellen Entwicklungen und die Gefahr für Deutschland.

Der Präsident des Robert-Koch-Instituts sprach am Donnerstag über das Coronavirus. Bayern habe die Krankheit erfolgreich eingedämmt. Es könne aber dennoch sein, dass man die Lage in Deutschland irgendwann nicht mehr unter Kontrolle habe.

In Köln muss ein Italien-Rückkehrer mit Verdacht auf Coronavirus ins Krankenhaus eingeliefert werden. Der Mann war in der Lombardei unterwegs gewesen.

Das Coronavirus breitet sich in Europa aus. Der Gesundheitsminister stellt die Deutschen auf Schlimmeres ein. Kliniken bereiten sich auf mehr Patienten vor.

Während alle Welt vor dem Coronavirus zittert, hat die diesjährige Grippewelle allein in Deutschland bereits 130 Tote gefordert. Insgesamt wurden in dieser Saison knapp 80.000 Erkrankungen gemeldet, die Hälfte davon in den vergangenen zwei Wochen.

Wie sollten Sie sich bei einem Verdacht auf Coronavirus verhalten? Was passiert mit Kontaktpersonen? Und wie lange dauert die Auswertung im Labor? Ein Überblick.

Ein Mann aus Starnberg in Bayern hat sich mit dem Coronavirus infiziert und wird behandelt. Das Risiko für die Bevölkerung in Deutschland wird aber „als gering erachtet“. In China steigt die Zahl der Todesopfer auf mehr als hundert.

Während der amerikanische Präsident Donald Trump in Davos viele Zuhörer erzürnt, beginnt in der Heimat das Impeachment-Verfahren gegen ihn. Außerdem im Podcast: der Corona-Virus und Rassismus-Vorwürfe bei den Simpsons.

Warum sind in Deutschland doppelt so viele junge Menschen depressiv wie im Rest Europas? Eine große Studie legt das nahe. Doch die Statistik ist trügerisch, was nicht zuletzt auch an den Ärzten liegt.

So viele Studierende wie nie zuvor sind psychisch krank. Dabei waren sie bisher eigentlich immer gesünder als andere ihres Alters. Was ist da passiert?

Nicht immer erhalten Menschen mit psychischen Erkrankungen die medizinische Behandlung, die sie benötigen. Digitale Angebote könnten diese Versorgungslücke zumindest zum Teil schließen. Besonders in Regionen, in denen Ärzte und Psychologen rar sind, können Patienten profitieren.

Nach den Listerienfunden beim Wurstwarenhersteller Wilke schaltet sich die Staatsanwaltschaft ein. Derweil ruht ein weiterer Wurstbetrieb wegen Bakterien-Verdachts, dieses Mal im Norden Deutschlands.

Die Zahl der Todesfälle durch Listerienkeime hatte im Fall des Wurstherstellers Wilke für Verwirrung gesorgt. Sie liegt inzwischen bei drei. Es ist nicht die einzige Merkwürdigkeit in diesem Fall.

Keime in Produkten des Wurstherstellers Wilke sollen für den Tod mehrerer Menschen verantwortlich sein. Die Verbraucherorganisation Foodwatch fordert eine vollständige Liste aller Abnehmer des Unternehmens und scheitert damit vor Gericht.

Der Skandal um den nordhessischen Wurst-Hersteller Wilke zieht noch weitere Kreise als bisher angenommen. Das Robert-Koch-Institut bestätigt drei Todesfälle außerhalb Hessens.

Verunreinigtes Fleisch steht in Verbindung mit zwei Toten in Hessen. Ein Ernährungswissenschaftler warnt im Skandal um Wursthersteller Wilke davor, „paranoid“ zu werden. Immer mehr Unternehmen nehmen Produkte aus dem Sortiment.

In Nordhessen sind zwei Menschen an Keimen in Wurst gestorben. Die Behörde hat das Unternehmen geschlossen.

Gesunde Psyche und gesunder Geist sind elementar für das Wohlbefinden eines Menschen. Deshalb sollten die steigende Häufigkeit von Depressionen bei Kindern und Jugenlichen ernst genommen werden. Gerd Schulte-Körne, Direktor der Klinik für Kinder- und Jugendpsychiatrie, Psychosomatik und Psychotherapie der Universität München, spricht über neue Untersuchungen und die Herausforderungen bei Depressionen.

In Nordrhein-Westfalen ist höchstwahrscheinlich der deutschlandweite Temperaturrekord gebrochen worden. Doch der Wert von 40,5 Grad könnte am Donnerstag schon wieder übertroffen werden. Experten erwarten einen extremen Tag – und warnen vor den Gefahren.

Sollten nur geimpfte Kinder Zugang zu Kitas haben dürfen? In Mainz will eine Einrichtung Kinder ohne entsprechende ärztliche Bescheinigung abweisen. Dabei ist die Lage rechtlich klar geregelt.

Zehntausende Tote gibt es jährlich aufgrund von multiresistenten Erregern. Obwohl sich Betroffene zumeist in Krankenhäusern infizieren, erhalten sie selten eine Entschädigung. Daran hagelt es Kritik.

In Deutschland gibt es für die dritthäufigste sexuell übertragbare Krankheit keine Meldepflicht. In Großbritannien hat sich die Zahl an Gonorrhö-Infektionen in wenigen Jahren auf rund 50.000 Fälle nahezu verdoppelt.

Immer mehr Menschen erkranken an ihr. Doch niemand spricht darüber. Milan Ammon schon. Die Geschichte eines Syphiliskranken.

Die Zahl der HIV-Infektionen sinkt, doch die Aufklärer stehen vor neuen Herausforderungen. Wie vertragen sich Online-Dating und Präventionsmedikamente für Hochrisikogruppen?

HIV-Positive leben dank moderner Behandlung heute so, als hätten sie sich nie infiziert. Sogar Sex ohne Kondom ist bei erfolgreicher Behandlung kein Problem mehr. Doch es ist eine lebensrettende Entwicklung mit gefährlichen Folgen.

Insgesamt lebten Ende 2017 rund 86.100 Menschen mit HIV in Deutschland. Besonders bei einer Gruppe sank die Zahl der Neuinfektionen deutlich. Tausende Menschen wissen laut einer Schätzung nicht, dass sie infiziert sind.

In manchen Gegenden wird der Impfstoff knapp. Was heißt das für die Grippe-Saison? Schwer vorauszusehen. Klar ist nur, wer am meisten von der vorbeugenden Spitze profitiert.
Während bei einer lebensbedrohlichen Sepsis andernorts ein Algorithmus eine Therapie empfiehlt, warten Ärzte hierzulande noch darauf. Es geht um Zehntausende Menschenleben. Können Mediziner auf solche Hilfe verzichten?

Gesundheitsminister Spahn war zu Besuch im Weißen Haus. Im Regierungssitz von Donald Trump traf sich der CDU-Politiker mit dessen Sicherheitsberater Bolton – und sprach mit ihm unter anderem über Bioterrorismus.